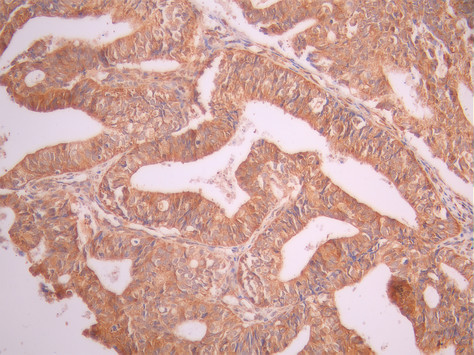

-
中文名稱:GBP1 Recombinant Monoclonal Antibody
-
貨號:CSB-RA986451A0HU
-
規格:¥1320
-
圖片:
-
Western Blot
, Positive WB detected in:A431 whole cell lysate(30μg), Jurkat whole cell lysate(30μg), U251 whole cell lysate(30μg), 786-O whole cell lysate(30μg)
All lanes: GBP1 antibody at 1:1000
Secondary
Goat polyclonal to rabbit IgG at 1/40000 dilution
Predicted band size: 68 kDa
Observed band size: 68 kDa
Exposure time:120s -
IHC image of CSB-RA986451A0HU diluted at 1:100 and staining in paraffin-embedded human thyroid tissue performed on a Leica BondTM system. After dewaxing and hydration, antigen retrieval was mediated by high pressure in a citrate buffer (pH 6.0). Section was blocked with 10% normal goat serum 30min at RT. Then primary antibody (1% BSA) was incubated at 4°C overnight. The primary is detected by a Goat anti-rabbit polymer IgG labeled by HRP and visualized using 0.05% DAB.
-
IHC image of CSB-RA986451A0HU diluted at 1:100 and staining in paraffin-embedded human ovarian cancer performed on a Leica BondTM system. After dewaxing and hydration, antigen retrieval was mediated by high pressure in a citrate buffer (pH 6.0). Section was blocked with 10% normal goat serum 30min at RT. Then primary antibody (1% BSA) was incubated at 4°C overnight. The primary is detected by a Goat anti-rabbit polymer IgG labeled by HRP and visualized using 0.05% DAB.
-
Overlay Peak curve showing 786-O cells stained with CSB-RA986451A0HU (red line) at 1:100. The cells were fixed in 4% formaldehyde and permeated by 0.2% TritonX-100 for 10min. Then 10% normal goat serum to block non-specific protein-protein interactions followed by the antibody (1ug/1*106cells) for 45min at 4℃. The secondary antibody used was FITC-conjugated goat anti-rabbit IgG (H+L) at 1/200 dilution for 35min at 4℃.Control antibody (green line) was Rabbit IgG (1ug/1*106cells) used under the same conditions. Acquisition of >10, 000 events was performed.
-
-
其他:
產品詳情
-
Uniprot No.:
-
基因名:
-
別名:GBP 1 antibody; GBP-1 antibody; GBP1 antibody; GBP1_HUMAN antibody; GTP binding protein 1 antibody; GTP-binding protein 1 antibody; Guanine nucleotide binding protein 1 antibody; Guanine nucleotide-binding protein 1 antibody; Guanylate binding protein 1 antibody; Guanylate binding protein 1 interferon inducible 67kDa antibody; Guanylate binding protein 1 interferon inducible antibody; HuGBP 1 antibody; HuGBP-1 antibody; HuGBP1 antibody; Interferon induced guanylate binding protein 1 antibody; Interferon-induced guanylate-binding protein 1 antibody; OTTHUMP00000012352 antibody
-
反應種屬:Human
-
免疫原:A synthesized peptide from human GBP1 protein
-
免疫原種屬:Homo sapiens (Human)
-
標記方式:Non-conjugated
-
克隆類型:Monoclonal
-
抗體亞型:Rabbit IgG
-
純化方式:Affinity-chromatography
-
克隆號:12E12
-
濃度:It differs from different batches. Please contact us to confirm it.
-
保存緩沖液:Rabbit IgG in 10mM phosphate buffered saline , pH 7.4, 150mM sodium chloride, 0.05% BSA, 0.02% sodium azide and 50% glycerol.
-
產品提供形式:Liquid
-
應用范圍:ELISA, WB, IHC, FC
-
推薦稀釋比:
Application Recommended Dilution WB 1:500-1:5000 IHC 1:50-1:200 FC 1:50-1:200 -
Protocols:
-
儲存條件:Upon receipt, store at -20°C or -80°C. Avoid repeated freeze.
-
貨期:Basically, we can dispatch the products out in 1-3 working days after receiving your orders. Delivery time maybe differs from different purchasing way or location, please kindly consult your local distributors for specific delivery time.
-
用途:For Research Use Only. Not for use in diagnostic or therapeutic procedures.
相關產品
靶點詳情
-
功能:Hydrolyzes GTP to GMP in 2 consecutive cleavage reactions. Exhibits antiviral activity against influenza virus. Promotes oxidative killing and delivers antimicrobial peptides to autophagolysosomes, providing broad host protection against different pathogen classes.
-
基因功能參考文獻:
- we have found GBP1 was downregulated during osteogenic differentiation of hBM-MSCs. While knockdown of GBP1 promoted osteogenesis, overexpression of GBP1 suppressed osteogenesis of hBM-MSCs. PMID: 29348519
- Here, we show that the human protein GBP1 acts as a cytosolic "glue trap," capturing cytosolic Gram-negative bacteria through a unique protein motif and preventing disseminated infections in cell culture models. To escape from this GBP1-mediated host defense, Shigella employs a virulence factor that prevents or dislodges the association of GBP1 with cytosolic bacteria. PMID: 29233899
- Results show that GBP1 is overexpressed in triple-negative breast cancer (TNBC), under the control of EGFR and selectively affects the growth of TNBC cell lines. PMID: 29115931
- hGBP1F acts as a nucleotide-controlled molecular switch by modulating the accessibility of its farnesyl moiety, which does not require any supportive proteins PMID: 28645896
- These findings confirm the involvement of caspase-1 in non-classical secretion mechanisms and open novel perspectives for the extracellular function of secreted GBP-1. PMID: 28272793
- Results suggest that guanylate-binding protein 1 (GBP1) plays a pivotal role in anti-T. gondii protection of mesenchymal stromal cells (hMSCs) and may shed new light on clarifying the mechanism of host defense properties of hMSCs. PMID: 28123064
- Shigella flexneri infection induces rapid proteasomal degradation of human guanylate binding protein-1 (hGBP1); the mode of IpaH9.8 action highlights the functional importance of GBPs in antibacterial defenses PMID: 29144452
- Previously reported tetrameric and dimeric species of hGBP-1 and hGBP-5 were unmasked as dimers and monomers, respectively, with their shapes depending on both the bound nucleotide and the ionic strength of the solution. PMID: 28580591
- Taken together, these results provide a new understanding of the antiviral mechanism of human GBP1, which possesses potent anti-Kaposi's sarcoma-associated herpesvirus activity, and suggest the critical role of viral RTA in the evasion of the innate immune response during primary infection by Kaposi's sarcoma-associated herpesvirus. PMID: 28592529
- A novel role for hGBP1 in cell-autonomous immunity that is independent of pathogen-containing vacuole translocation. PMID: 26874079
- Elevated hGBP-1 RNA in ovarian tumors correlates with shorter recurrence-free survival. hGBP-1 does not confer paclitaxel resistance on MCF-7 and TMX2-28 breast cancer cells. PMID: 27590579
- the study not only highlights the importance of hGBP1 tetramer in stimulated GMP formation, but also demonstrates its role in the antiviral activity against hepatitis C virus. PMID: 27071416
- GBP1 expression is elevated in human Glioblastoma multiforme tumors and positively correlates with EGFRvIII status in Glioblastoma multiforme specimens, and its expression is inversely correlated with the survival rate of Glioblastoma multiforme patients. Taken together, these results reveal that GBP1 may serve as a potential therapeutic target for Glioblastoma multiforme with EGFRvIII mutation. PMID: 26848767
- GBP1 promotes lymph node metastasis and has a positive correlation with EGFR expression in esophageal squamous cell carcinoma. PMID: 26760981
- Molecular dynamics studies showed that only GTP decreases the formation of the GBP1:PIM1 complex through an allosteric mechanism, outlining the rational for the identification of new compounds potentially able to revert resistance to paclitaxel. PMID: 25081641
- GBP1 overexpression is necessary for the radioresistant phenotype in clinically relevant radioresistant cells PMID: 25098609
- data show that dimer formation of hGBP1 involves multiple spatially distant regions of the protein, namely, the N-terminal LG domain and the C-terminal helices alpha13. PMID: 24991938
- GBP-1 is a downstream processor of IFN-gamma. PMID: 24337748
- GBP-1 is a novel member within the family of actin-remodeling proteins specifically mediating IFN-gamma-dependent defense strategies. PMID: 24190970
- IFN-gamma-induced Guanylate Binding Protein-1 is a novel Actin Cytoskeleton Remodeling Factor. GBP-1 may induce actin remodeling via globular actin sequestering and/or filament capping. GBP-1 is a novel member within the family of actin remodeling proteins, specifically mediating IFN-gamma-dependent defense strategies. PMID: 24190970
- Data indicate that among three deductive p53 response element (p53RE) present in the hGBP1 promoter region, two p53REs were found to be transactivated by p53. PMID: 23727578
- GBP1/2 are critical effectors of antichlamydial interferon (IFN)gamma-mediated pathogen clearance via rerouting of bacterial inclusions in macrophages for lysosomal degradation. PMID: 23086406
- Thermodynamic insight as to how the stability of an intermediate catalytic complex regulates the product formation in hGBP1. PMID: 22859948
- Cytokine-induced GBP-1 retards cell proliferation by forming a negative feedback loop that suppresses beta-catenin / TCF signaling. PMID: 22692453
- results suggested that GBP-1 acts directly as a tumor suppressor in CRC and the loss of GBP-1 expression might indicate tumor evasion from the IFN-gamma-dominated Th1 immune response. PMID: 23042300
- GBP1 inhibits proliferation, migration, invasion and tumor formation of colon tumor cells. PMID: 23042300
- Data indicate that alpha12/13 represents a stable subdomain of guanylate-binding protein 1 (hGBP1). PMID: 22607347
- Data indicate that GBP1 guanine cap (i.e., C-terminal guanine-binding amino acid motif, particularly Arg240/Arg244) is key structural element responsible for dimerization and is essential for self-activation of GTPase activity. PMID: 22059445
- higher GBP1 level in oral cavity squamous cell carcinoma tissue was associated with higher overall pathological stage, positive perineural invasion, and poorer prognosis PMID: 21714544
- establish GBP1 as a previously unknown link between EGFR activity and MMP1 expression and nominate it as a novel potential therapeutic target for inhibiting GBM invasion. PMID: 22162832
- Data indicate that GBP-1 contributes to vascular dysfunction in chronic inflammatory diseases by inhibiting endothelial progenitor cell (EPC) angiogenic activity via the induction of premature EPC differentiation. PMID: 20716116
- GBP-1 cellular 1ocalization depends on prenylation and dimerization. PMID: 21151871
- hGBP-1, hGBP-2 showed dimerization-related GTPase activity for GMP formation. PMID: 20923658
- Animals carrying murine mammary carcinoma cells that had been given doxycycline for induction of human GBP-1 expression revealed a significantly reduced tumor growth compared with mock-treated mice. PMID: 20454519
- Results identify intramolecular contacts of guanylate binding protein 1, which relay nucleotide-dependent structural changes from the N-terminus to the C-terminus and thereby mediate tetramer formation of the protein. PMID: 20450919
- These findings identify a role for IFN-alphaA-mediated GBP-1 expression in the prevention of intestinal epithelial apoptosis by commensal bacteria. PMID: 20483731
- designed point mutants in the phosphate-binding loop (P-loop) as well as in the switch I and switch II regions. These mutant proteins were analysed for their interaction with guanine nucleotides and for their ability to hydrolyse GTP. PMID: 15504415
- Golgi targeting of human guanylate-binding protein-1 requires nucleotide binding, isoprenylation, and an IFN-gamma-inducible cofactor. PMID: 15937107
- GBP-1 regulates anti-proliferative effect of inflammatory cytokines. It also mediates inhibition of endothelial cell invasiveness by down regulation of MMP-1[review] PMID: 16005050
- crystal structures of the N-terminal G domain trapped at successive steps along the reaction pathway and biochemical data reveal the molecular basis for nucleotide-dependent homodimerization and cleavage of GTP PMID: 16511497
- kinetic investigation of GTP hydrolysis catalyzed by interferon-gamma-induced hGBP1 PMID: 16873363
- Interferon-alpha upregulates GBP1 in cultured human vascular endothelial cells. PMID: 16894355
- 3 genes were upregulated in patients with chronic EBV infection: guanylate binding protein 1, tumor necrosis factor-induced protein 6, and guanylate binding protein 5; they may be associated with the inflammatory reaction or with cell proliferation. PMID: 18260761
- GBP-1 may be a novel biomarker and an active component of a Th-1-like angiostatic immune reaction in colorectal carcinoma. PMID: 18697200
- GBP-1 is a novel marker of intestinal mucosal inflammation that may protect against epithelial apoptosis induced by inflammatory cytokines and subsequent loss of barrier function PMID: 19079332
- The authors demonstrate for the first time that both the alpha-helix of the intermediate region and the (103)DXEKGD(108) motif play critical roles for the hydrolysis to GMP. PMID: 19150356
- The results indicate that the GBP1, STAT1 and CXCL10 may be novel risk genes for the differentiation of PBM at the monocyte stage. PMID: 19223260
- Positions of cysteine residues buried between the C-terminal domain of GBP1 and the rest of the protein are identified which report a large change of accessibility by the compound after addition of GTP. PMID: 19463820
- Inhibition of endothelial cell spreading and migration by inflammatory cytokines is mediated by GBP-1 through induction of ITGA4 expression. PMID: 18697840
- Human guanylate binding protein-1 may be a useful surrogate marker for diagnosis of bacterial meningitis PMID: 16936281
顯示更多
收起更多
-
亞細胞定位:Cytoplasm. Golgi apparatus membrane; Lipid-anchor; Cytoplasmic side. Cell membrane. Secreted. Note=Secreted from endothelial cells in the cerebrospinal fluid, upon bacterial challenge and independently of IFNG induction. Golgi membrane localization requires isoprenylation and the presence of another IFNG-induced factor.
-
蛋白家族:TRAFAC class dynamin-like GTPase superfamily, GB1/RHD3-type GTPase family, GB1 subfamily
-
數據庫鏈接:
Most popular with customers
-
-
YWHAB Recombinant Monoclonal Antibody
Applications: ELISA, WB, IHC, IF, FC
Species Reactivity: Human, Mouse, Rat
-
Phospho-YAP1 (S127) Recombinant Monoclonal Antibody
Applications: ELISA, WB, IHC
Species Reactivity: Human
-
-
-
-
-